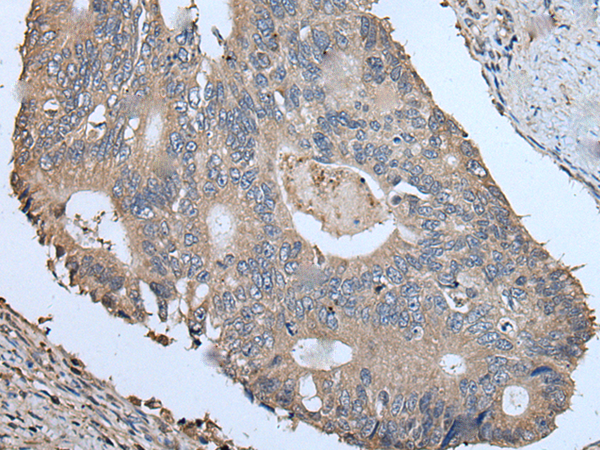

英文名稱: Anti-IQGAP1 rabbit polyclonal antibody
級 別: SAR1; p195; HUMORFA01
克隆類型: rabbit polyclonal
Background:
This gene encodes a member of the IQGAP family. The protein contains four IQ domains, one calponin homology domain, one Ras-GAP domain and one WW domain. It interacts with components of the cytoskeleton, with cell adhesion molecules, and with several signaling molecules to regulate cell morphology and motility. Expression of the protein is upregulated by gene amplification in two gastric cancer cell lines.
Applications:
ELISA, WB, IHC
Name of antibody:
IQGAP1
Immunogen:
Synthetic peptide of human IQGAP1
Full name:
IQ motif containing GTPase activating protein 1
Synonyms:
SAR1; p195; HUMORFA01
SwissProt:
P46940
ELISA Recommended dilution:
5000-10000
IHC positive control:
Human cervical cancer
IHC Recommend dilution:
25-100
WB Predicted band size:
189 kDa
WB Positive control:
HUVEC cell lysate
WB Recommended dilution:
500-2000
技術(shù)規(guī)格

購物車
幫助
021-54845833/15800441009
